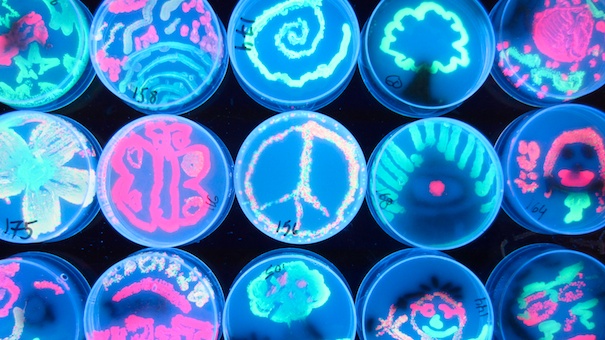

Osservando l’evoluzione più recente della ricerca medica e biologica, si rimane stupiti non solo per gli straordinari progressi compiuti dalla scienza, ma anche per il modo nuovo in cui queste comunità scientifiche si organizzano e dialogano con il resto della società. Mentre il dibattito pubblico sulle ricadute sociali della scienza sembra incagliato su alcuni temi evergreen (le colture geneticamente modificate, l’uso delle cellule staminali, le biotecnologie in campo riproduttivo), cittadini ed esperti sperimentano nuove relazioni di cui Alessandro Delfanti, in Biohacker. Scienza aperta e società dell’informazione (Elèuthera), ci dà un resoconto tempestivo. Per quanto accesi, i dibattiti citati non avevano scalfito più di tanto l’immagine del ricercatore rispetto a quella «classica». Già negli anni ’40, infatti, il sociologo Robert K. Merton aveva individuato una sorta di galateo degli scienziati fondato su universalismo, condivisione dell’informazione, disinteresse economico e riproducibilità degli esperimenti.
Un simile codice di comportamento divideva nettamente in due la comunità scientifica: da un lato i «buoni», prevalentemente attivi nel settore statale e nella ricerca di base; dall’altro i «cattivi», al servizio delle industrie interessate a ricavare profitto dalle applicazioni delle scoperte piuttosto che a collaborare con i potenziali concorrenti. Oggi questa distinzione è venuta meno, grazie soprattutto a tecnologie digitali di elaborazione e circolazione dell’informazione di inedita efficacia che hanno connesso settori scientifici (e non) prima separati. Allo stesso tempo, però, nuove linee di frattura sono emerse: una fra tutte, quella tra scienza «aperta» e «chiusa». Per illustrare il mutamento, Delfanti illustra alcuni casi singolari provenienti tutti dall’ambito delle scienze della vita.
La virologa Daria Capua, grazie alla sua ribellione contro le grandi istituzioni sanitarie internazionali, ha fatto in modo che le sequenze genetiche necessarie per monitorare la diffusione dell’influenza aviaria (quella che fece parlare di pandemia nel 2006) fossero messe a disposizione di tutti gli scienziati, invece di rimanere chiuse in una banca dati dell’Organizzazione Mondiale della Sanità (Oms) ad accesso riservato. Il genetista-imprenditore (e surfista) Craig Venter percorre gli oceani a bordo del suo yacht-laboratorio Sorcerer II. Tra un tuffo e l’altro, raccoglie dati genetici sui micro-organismi marini e costruisce il più grande database genomico al mondo che chiunque può consultare. Grazie a quei dati e al suo know-how, Venter ha depositato diverse domande di brevetto su «batteri sintetici» ad uso industriale.
II movimento transnazionale Do- it-yourself biology (www.diybio.org), cioè «Biologia Fai-da-te», promuove il libero uso delle biotecnologie, finora monopolizzate dalle grandi imprese: a questo scopo costruisce attrezzature di laboratorio che permettono di sperimentare la propria creatività manipolando batteri, cellule e geni nel garage di casa. Salvatore laconesi, artista multimediale e hacker, scoperto di avere un tumore al cervello, ha «craccato» la sua stessa cartella clinica per condividerla in un formato open source accessibile a qualunque medico possa rivelarsi utile. laconesi ha potuto ottenere attraverso la rete informazioni preziose per la sua terapia, fornendo una dimostrazione delle chance aperte dagli «open data». I casi analizzati da Delfanti mettono in discussione il mito sinistrorso della «ricerca pubblica». Se finora questa espressione era legata alla natura del committente, la biologia odierna suggerisce che le regole del gioco siano ancor più importanti di chi mette i soldi per stipendi e laboratori.
Anzi, la residua sovranità nazionale ostacola la libertà di ricerca tanto quanto il mercato. La scienza aperta spesso si muove contro, più che dentro, le burocrazie statali. Per ottenere che i dati sull’influenza fossero resi accessibili, Capua ha dovuto combattere (e vincere) contro i vertici di un’istituzione pubblica per antonomasia come l’Oms. Analogamente, lo spettro del bioterrorismo viene agitato dal governo Usa per finanziare ricerca di base e cosl rilanciare l’industria farmaceutica (privata) in crisi. Ma ha provocato anche l’arresto e la condanna dei «biohacker del Criticai Art Ensemble, colpevoli di aver realizzato performance in cui semplici cittadini potevano sintetizzare Dna. E mentre sono proprio i governi a spingere i ricercatori pubblici verso la brevettazione dei loro risultati, un settore crescente dell’industria privata high tech scopre le virtù della condivisione: colossi farmaceutici come AstraZeneca, Pfizer e Merck finanziano e alimentano banche-dati aperte a disposizione dei biotecnologi.
Non si tratta di un’alleanza in nome del bene comune, ma di un nuovo equilibrio tra pubblico e privato che si fa strada con molte contraddizioni. È ciò che fa dire a Venter. «Il mio successo più grande è stato farmi odiare da entrambi i mondi». Il vero motore di questa trasformazione è la cultura fondata sul pieno accesso all’informazione, sulla sfiducia per l’autorità e sulla partecipazione attiva all’innovazione mutuata dall’informatica (open source». Negli scienziati questi valori sono andati via via sbiadendo. Gli hacker» li hanno fatti propri e conservai in attesa di tempi migliori, come un virus in provetta pronto a diffondersi. E ora qualcuno ha aperto il laboratorio.

L’Associazione Luca Coscioni è una associazione no profit di promozione sociale. Tra le sue priorità vi sono l’affermazione delle libertà civili e i diritti umani, in particolare quello alla scienza, l’assistenza personale autogestita, l’abbattimento della barriere architettoniche, le scelte di fine vita, la legalizzazione dell’eutanasia, l’accesso ai cannabinoidi medici e il monitoraggio mondiale di leggi e politiche in materia di scienza e auto-determinazione.